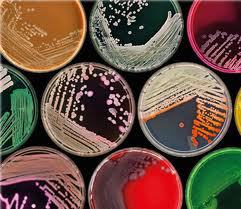

Science / Combined Science
Science can be described in a number of ways.
Science (from Latin scientia, meaning "knowledge") is a systematic enterprise that builds and organizes knowledge in the form of testable explanations and predictions about the universe.
In an older and closely related meaning (explained by Aristotle), "science" refers to the body of reliable knowledge itself, of the type that can be logically and rationally explained.
The study of Science is the systematic observation of natural events and conditions in order to discover facts about them and to formulate laws and principles based on these facts.
A primary aim of science is to collect facts (data) through observation and experimentation. This involves using Scientific Method. In addition both precision and accuracy are needed when collecting
scientific data during experiments.
An ultimate purpose of science is to discern the order that exists between and amongst the various facts.
Science is an intellectual activity carried on by humans that is designed to discover information about the natural world in which humans live and to discover the ways in which this information can be organized into meaningful patterns.
Science is an intellectual activity carried on by humans that is designed to discover information about the natural world in which humans live and to discover the ways in which this information can be organized into meaningful patterns.
Science gives us the knowledge to explain what we see happening in the world around us.
Science involves more than the gaining of knowledge. It is the systematic and organized inquiry into the natural world and its phenomena. Science is about gaining a deeper and often useful understanding of the world.
Science involves more than the gaining of knowledge. It is the systematic and organized inquiry into the natural world and its phenomena. Science is about gaining a deeper and often useful understanding of the world.
Science is a way of discovering what's in the universe and how those things work today, how they worked in the past, and how they are likely to work in the future. Scientists are motivated by the thrill of seeing or working out something that no one has before.
Science refers to a system of acquiring knowledge. This system uses observation and experimentation to describe and explain natural phenomena. The term science also refers to the organized body of knowledge people have gained using that system.
Science refers to a system of acquiring knowledge. This system uses observation and experimentation to describe and explain natural phenomena. The term science also refers to the organized body of knowledge people have gained using that system.